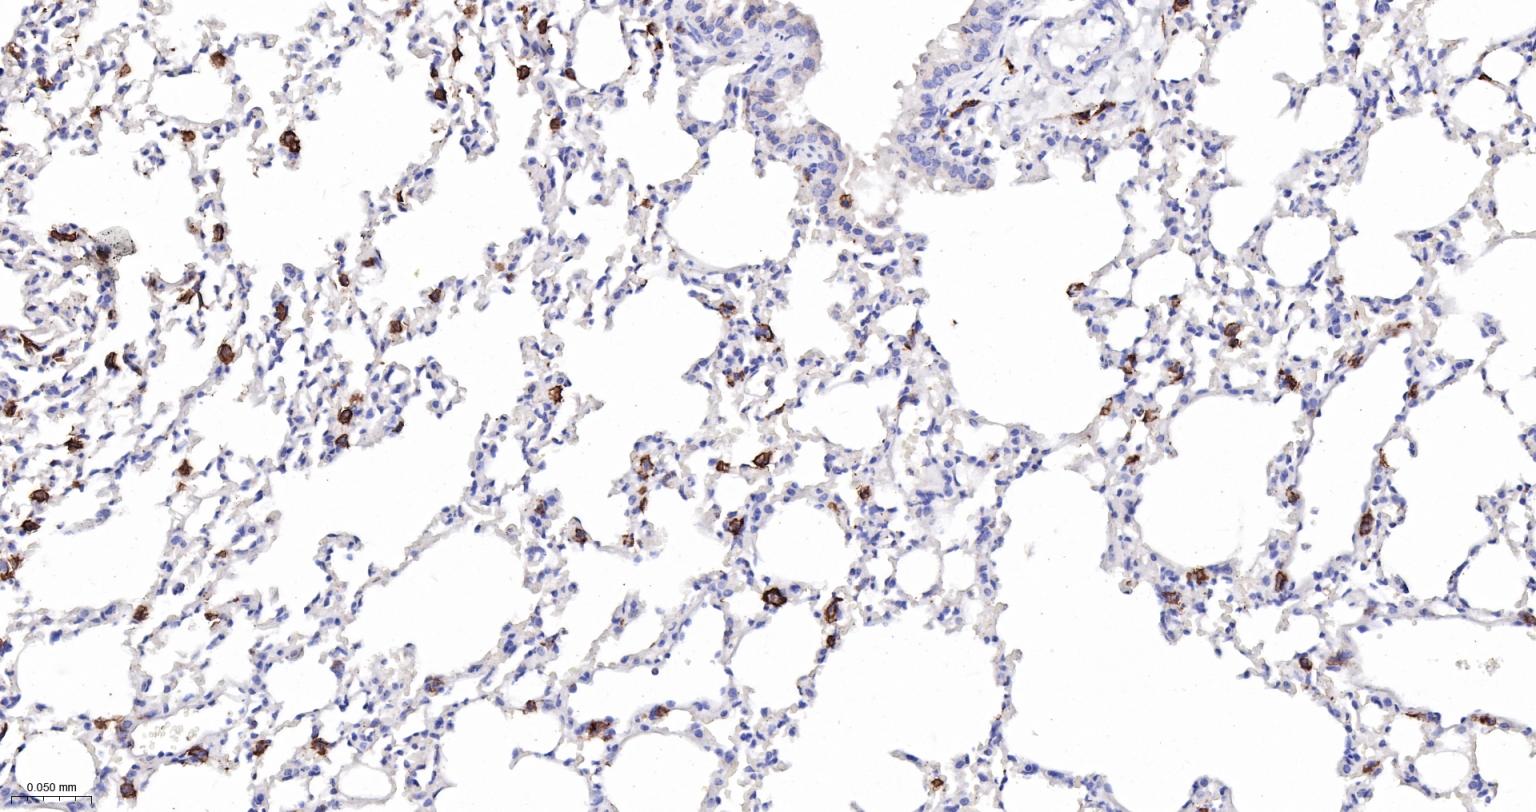
整合素αX重组兔单抗-bsm-55624R

CD11c Recombinant Rabbit mAb (一抗) - WB,IHC-P,IHC-F,IF | Bioss
Rrmab?兔单抗

货号:bsm-55624R
产品详情
相关标记
相关产品
相关文献
常见问题
概述
产品编号
bsm-55624R
产品类型
重组兔单抗、mIHC精品抗体
英文名称
CD11c Recombinant Rabbit mAb
中文名称
整合素αX重组兔单抗
英文别名
CD11C; SLEB6; Cr4; N418; RGD1561123; ITAX_HUMAN; ITGAX; CD11 antigen-like family member C; Leu M5; Leukocyte adhesion glycoprotein p150,95 alpha chain; Leukocyte adhesion receptor p150,95; ITAX_MOUSE; integrin subunit alpha X; integrin, alpha X (antigen CD11C (p150), alpha polypeptide); integrin, alpha X (complement component 3 receptor 4 subunit); complement component 3 receptor 4 subunit
抗体来源
Rabbit
免疫原
Recombinant mouse CD11c protein
亚型
IgG
性状
Liquid
纯化方法
affinity purified by Protein A
克隆类型
Recombinant
克隆号
11G3
理论分子量
129 kDa
检测分子量
145 kDa
浓度
1mg/ml
储存液
0.01M TBS (pH7.4) with 1% BSA, 0.02% Proclin300 and 50% Glycerol.
研究领域
Immunology > Cell Type Markers > CD > Adhesion
Signal Transduction > Cytoskeleton / ECM > Cell Adhesion > Integrins > Alpha
Stem Cells > Hematopoietic Progenitors > Lymphoid > T Lymphocytic Lineage
Stem Cells > Hematopoietic Progenitors > Myeloid > Dendritic Cell Lineage
Stem Cells > Hematopoietic Progenitors > Myeloid > Monocytic Lineage
SWISS
Gene ID
保存条件
Shipped at 4℃. Store at -20℃ for one year. Avoid repeated freeze/thaw cycles.
注意事项
This product as supplied is intended for research use only, not for use in human, therapeutic or diagnostic applications.
数据库链接
背景资料
This gene encodes the integrin alpha X chain protein. Integrins are heterodimeric integral membrane proteins composed of an alpha chain and a beta chain. This protein combines with the beta 2 chain (ITGB2) to form a leukocyte-specific integrin referred to as inactivated-C3b (iC3b) receptor 4 (CR4). The alpha X beta 2 complex seems to overlap the properties of the alpha M beta 2 integrin in the adherence of neutrophils and monocytes to stimulated endothelium cells, and in the phagocytosis of complement coated particles. [provided by RefSeq].

产品应用
| 应用 | 已检合格种属 | 预测种属 | 推荐稀释比例 |
|---|---|---|---|
| WB | Mouse | 1:500-2000 | |
| IHC-P | Mouse | 1:200-1000 | |
| IHC-F | Mouse | 1:200-1000 | |
| IF | Mouse | 1:200-1000 |
交叉反应
交叉反应: Mouse
相关产品
暂无相关产品
靶标
基因名
ITGAX
蛋白名
Integrin alpha-X
亚细胞定位
Membrane.
组织特异性
Predominantly expressed in monocytes and granulocytes.
相似性
Belongs to the integrin alpha chain family.
Contains 7 FG-GAP repeats.
Contains 1 VWFA domain
Contains 7 FG-GAP repeats.
Contains 1 VWFA domain
功能
Integrin alpha-X/beta-2 is a receptor for fibrinogen. It recognizes the sequence G-P-R in fibrinogen. It mediates cell-cell interaction during inflammatory responses. It is especially important in monocyte adhesion and chemotaxis.
同靶标产品
相关文献
提示: 发表研究结果有使用 bsm-55624R 时请让我们知道,以便我们可以引用参考文章。作为回馈,资料提供者将获得我们送上的小礼品。